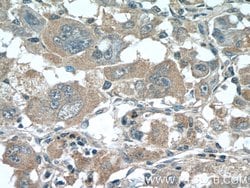
SLC30A8/ZNT8 Rabbit anti-Human, Mouse, Rat, Polyclonal, Proteintech 150

missing translation for 'onlineSavingsMsg'
Learn More
Learn More
SLC30A8/ZNT8 Rabbit anti-Human, Mouse, Rat, Polyclonal, Proteintech
Rabbit Polyclonal Antibody
Brand: Proteintech 16169-1-AP-150UL
This item is not returnable.
View return policy
Description
Slc30A8 is a zinc efflux transporter involved in the accumulation of zinc in intracellular vesicles and is expressed at a high level in the pancreas, particularly in islets of Langerhans, and co-localizes with insulin in the secretory pathway granules of the insulin-secreting INS-1 cells. Allelic variants of Slc30A8 have been identified as major genetic risk factors for the development of Type 2 diabetes, but no genetic association has been found with Type 1 diabetes. Slc30A8 expression in b-cells was found to be influenced by cytokine expression, particularly IFN-gamma and IL-1 beta.Specifications
| SLC30A8/ZNT8 | |
| Polyclonal | |
| Unconjugated | |
| SLC30A8 | |
| SLC30A8, Zinc transporter 8, ZnT 8, ZNT8 | |
| Rabbit | |
| Antigen Affinity Chromatography | |
| RUO | |
| 169026, 239436, 299903 | |
| -20°C | |
| Liquid |
| Immunohistochemistry (Paraffin), Western Blot | |
| 0.22 mg/mL | |
| PBS with 50% glycerol and 0.02% sodium azide; pH 7.3 | |
| P0CE46, Q8BGG0, Q8IWU4 | |
| Slc30a8 | |
| Peptide | |
| 150 μL | |
| Primary | |
| Human, Mouse, Rat | |
| Antibody | |
| IgG |
Product Content Correction
Your input is important to us. Please complete this form to provide feedback related to the content on this product.
Product Title
Spot an opportunity for improvement?Share a Content Correction